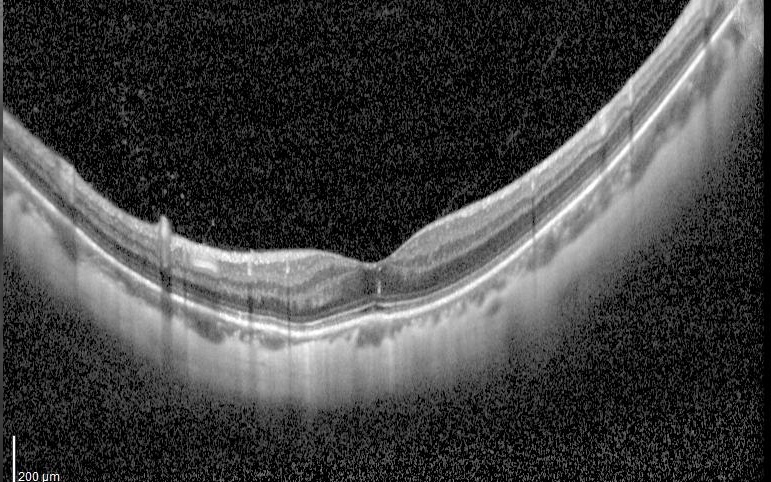
我和来自美国求医的Jason过了一个虚惊一场的父亲节

今天上午一大早刷手机时突然跳出来Jason差不多一分钟的留言。我突然心头一紧,这个Jason又怎么啦?他不是星期四晚上才跟我联系过说下周一上午再来跟我确认第二眼手术到底选择三焦人工晶状体还是单焦人工晶状体的吗?
难道会有什么大问题出现吗?
一个月以前的一天Jason联系到我,他告诉我他是一位生活在美国加州的中国人,曾经是一名内科医生。由于双眼有2000多度的超高度近视眼,一直想通过手术解决,但是由于美国这样的超高度近视眼患者病例少见,他一直下不了决心。突然有一天他在头条上刷到我曾经为一位2200度超高度近视眼手术以后学习开飞机的新闻,就下定决心要回国来找我做手术。

5月中旬他回国以后,经过我详细检查和他深入交流,可以考虑装三焦点人工晶状体一次性解决他超高度近视眼和老花眼的问题,并且把手术以后可能出现的多功能人工晶状体诸如炫光和视蒙等需要与大脑适应等情况一边当面告诉他,还一边通过手机语音留言功能同时发给他回家以后继续听。
由于他和爱人都是学医出身,当然关注最严重的手术并发症是什么?我告诉他们就是手术以后出现感染性眼内炎,发生率约2~5/万。根据我的经验手术以后眼睛不进水的话一般不发生,另外即使是发生了我也能力把它抢救过来,因为到目前为止,我自己20多年临床工作中出现过的13例眼内炎确实全部抢救成功了。
一切准备就绪以后,2023年6月12日,我给他右眼成功实施了FLACS+三焦点人工晶状体植入手术。手术以后远、中、近视力分别为0.6、0.63和1.0,还是比较满意出院了。出院几天以后就不断问我为什么看手机感觉是既看清楚又看不清楚,实际上根据出院时的检查结果他的近视力1.0非常好,就是手术以前我跟他交代过的视蒙等需要与大脑适应的问题,我就回复他可以返回去听我手术以前跟他交流过的语音内容,没有特别的情况例如视力明显下降等问题的话就完全不用担心,继续观察就可以了。但是如果视力明显下降的话,一定要及时联系我,否则就会耽误病情。
想到这里,我马上点开了他的语音,他在留言告诉我手术过的右眼早上起来感觉视力明显下降看不清了,还有有一点异物感和红。我一听到这个消息,就感觉大事不好,大概率是眼睛又发炎了。我马上告诉他8点钟过来看一下,先做相关检查,我今天在上海,马上就会过去给他看。

他们8:55到了医院以后立刻做了相关检查,我差不多9点多也到了医院。等他检查完以后到我诊室一看,矫正视力只有0.15,轻度充血,角膜轻度水肿,房水轻度混浊,前房和瞳孔区有明显的渗出物,眼底模糊不清。我马上问他,这两天有没有洗澡,他说昨天下午洗澡了,但是洗澡时手术过的眼睛用毛巾保护住了,确认没有进水。我结合了相关的客观检查认为主要还是眼前段的炎症反应,当时就判断很大可能是一个非感染性的炎症反应,但是也不能完全排除感染性眼内炎。先紧急处理观察三个小时左右再根据病情变化决定下一步的治疗措施等。



我一边安抚好病人及家属(他们表示理解,一切听我安排),一边跟医院相关领导通报情况,一边通知手术和医生团队做好抢救准备,一边在焦急地等待着三个小时以后的判决。
今天是父亲节,本来是计划好星期六上午参加完上海第十人们医院眼科高峰论坛讲课任务以后要回厦门看女儿的,后来是因为医院有接待计划就取消了厦门之旅。
很庆幸,还好我今天在上海,不仅不然病人及家属会很紧张,我在厦门也肯定是提心吊胆啦!这个父亲节肯定只能在诚惶诚恐之中度过啦。
终于等到了12:30结果出来了,患者经过三个多小时的滴眼水治疗,患者自我感觉也亮了,视力提高到了0.5,前节反应明显减轻,眼后段没有波及,基本上证实了我三个半小时以前的判断。

真是虚惊一场!大家看到这个结果,尤其是患者和家属悬着的心终于可以放下了。我认为我自己也兑现了自己对所有病人的承诺“一定会为了患者的光明竭尽全力”!
Jason笑哈哈地说,“我们专程从美国来找李院长就是信任您,您给我们放心和安心!”
13点14,父亲节,我最想收到的祝福也如期而至!感谢来自女儿的祝福!

最后,祝Jason尽快恢复光明及天下所有的父亲们父亲节快乐!